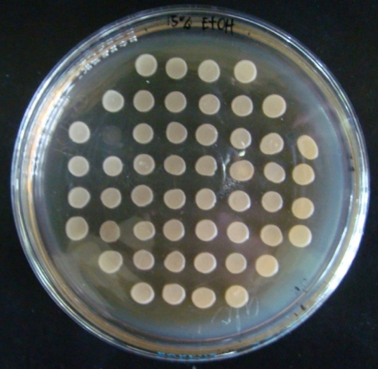
Picture4

Philipp. Sci. Lett. 10 (1) 22-28
available online: March 14, 2017
*Corresponding author
Email Address: florosco@upd.edu.ph
Received: 30 May 2016
Revised: 07 October 2016
Accepted: 06 November 2016
Bioethanol production has been the center of interest of scientists to generate a more sustainable, low cost and environment-friendly fuel compared to petroleum fuel products. However, a more robust and high performing ethanologen still needs to be developed to effectively convert sugars to ethanol while withstanding chemical and thermal stress. In this study, genome shuffling through ethyl methanesulfonate (EMS) mutagenesis and protoplast fusion was performed to develop superior strains of Saccharomyces cerevisiae 2013 with improved ethanol tolerance, thermotolerance and ethanol production. Results of the experiment obtained eight promising strains. These isolates exhibited higher ethanol yield compared to the parental strain at 30 °C and 42 °C. Furthermore, these isolates remained stable and viable up to 42 °C in 15 % (w v⁻¹) to 18 % (w v⁻¹) ethanol. Data on presence of trehalose content further supported these observations. Improved strain, F1D, was found to be the most promising isolate being able to grow at 42 °C and 18 % ethanol and yielding 10.83 % higher ethanol than parental strain 2013 and 15.16 % over the industrial strain S. cerevisiae HBY3. Thus, genome shuffling is a powerful tool in developing S. cerevisiae 2013 strains with improved fermentation qualities.
© 2026 SciEnggJ
Philippine-American Academy of Science and Engineering